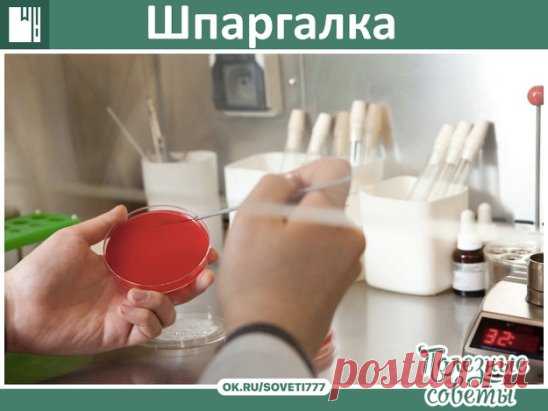
Шпаргалка
Никогда не давать антибиотик ДО того как на руки не получите анализ крови с лейкоформулой. 
Запомните, напишите себе где то на видном месте!!! 
ПОВЫШЕНИЕ лейкоцитов, СОЭ, лимфоцитов - ВИРУС 
ПОВЫШЕНИЕ лейкоцитов, СОЭ, нейтрофилов сегметоядерных и палочкоядерных + СНИЖЕНИЕ лимфоцитов - БАКТЕРИЯ 
без повышения нейтрофилов бактериальной инфекции НЕ БЫВАЕТ. Запомните это. Если вам сделали анализ без лейкоформулы, но вы видите, что лейкоцитов, к примеру, 15,4, а лимфоцитов 15-20, то уже с б

ok.ru
11.02.2018, 22:10:20
Шпаргалка Никогда не давать антибиотик ДО того как на руки не получите анализ крови с лейкоформулой. Запомните, напишите себе где то на видном месте!!! ПОВЫШЕНИЕ лейкоцитов, СОЭ, лимфоцитов - ВИРУС ПОВЫШЕНИЕ лейкоцитов, СОЭ, нейтрофилов сегметоядерных и палочкоядерных + СНИЖЕНИЕ лимфоцитов - БАКТЕРИЯ без повышения нейтрофилов бактериальной инфекции НЕ БЫВАЕТ. Запомните это. Если вам сделали анализ без лейкоформулы, но вы видите, что лейкоцитов, к примеру, 15,4, а лимфоцитов 15-20, то уже с б
Шпаргалка
Никогда не давать антибиотик ДО того как на руки не получите анализ крови с лейкоформулой.
Запомните, напишите себе где то на видном месте!!!
ПОВЫШЕНИЕ лейкоцитов, СОЭ, лимфоцитов - ВИРУС
ПОВЫШЕНИЕ лейкоцитов, СОЭ, нейтрофилов сегметоядерных и палочкоядерных + СНИЖЕНИЕ лимфоцитов - БАКТЕРИЯ
без повышения нейтрофилов бактериальной инфекции НЕ БЫВАЕТ. Запомните это. Если вам сделали анализ без лейкоформулы, но вы видите, что лейкоцитов, к примеру, 15,4, а лимфоцитов 15-20, то уже с б
